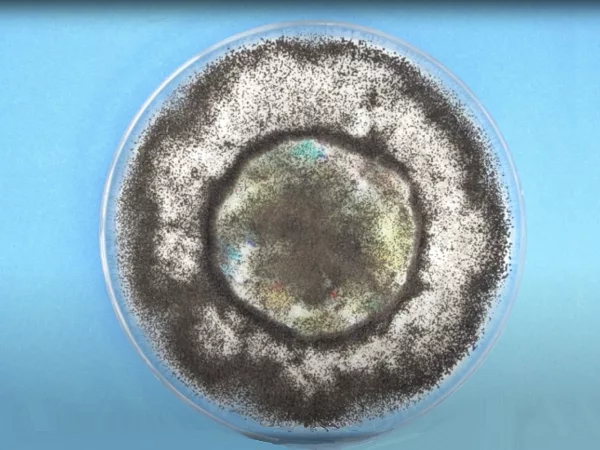
Untreated rebond foam
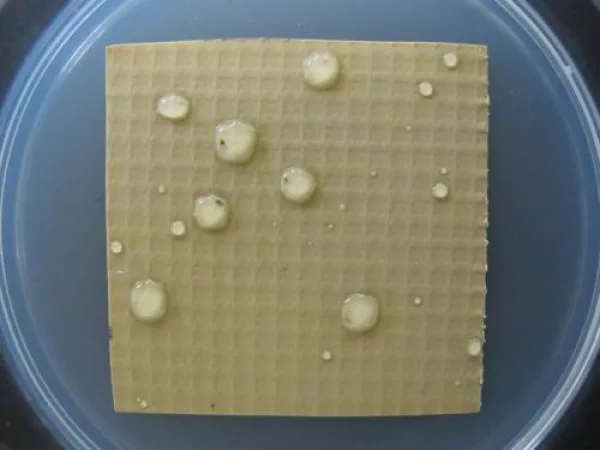
Vinyl treated with Ultra-Fresh

![Vinyl with Competitor Antimicrobial]()
Vinyl with Competitor Antimicrobial
Vinyl treated with competitor biocide after testing using the ASTM G21
![Vinyl treated with Ultra-Fresh]()
Vinyl treated with Ultra-Fresh
Vinyl treated with Ultra-Fresh after testing using the ASTM G21
![Kitchen sponge without antimicrobial treatment]()
Kitchen sponge without antimicrobial treatment
Cellulose kitchen sponge with fungal growth after testing using the AATCC Method 30, Part III
![Ultra-Fresh antimicrobal treated kitchen sponge]()
Ultra-Fresh antimicrobal treated kitchen sponge
A cellulose sponge treated with Ultra-Fresh demonstrates excellent antifungal properties. Tested using the AATCC Method 30, Part III
![Vinyl treated with competitor antimicrobial, stained pink]()
Vinyl treated with competitor antimicrobial, stained pink
Vinyl treated with a competitor biocide does not have adequate antimicrobial protection and becomes stained pink after testing using the ASTM E1428 (Streptoverticillium reticulum)
![Vinyl treated with Ultra-Fresh, no pink staining after testing using the ASTM E1428.]()
Vinyl treated with Ultra-Fresh, no pink staining after testing using the ASTM E1428.
Ultra-Fresh treated vinyl remains clean and unstained after testing using the ASTM E1428 (Streptoverticillium reticulum)
![Wood coating without antimicrobial treatment]()
Wood coating without antimicrobial treatment
Untreated wood coating supports fungal growth after testing using the AATCC Method 30, Part III
![Antimicrobial coating on wood with Ultra-Fresh]()
Antimicrobial coating on wood with Ultra-Fresh
Wood coating treated with Ultra-Fresh antimicrobial remains free from growth after testing using the AATCC Method 30, Part III
![Adhesive without antimicrobial treatment]()
Adhesive without antimicrobial treatment
Untreated adhesive that is showing visible signs of spoilage
![Adhesive with Ultra-Fresh]()
Adhesive with Ultra-Fresh
Adhesive treated with Ultra-Fresh antimicrobial treatment prevents "in-can" microbial spoilage
![Feathers without antimicrobial treatment]()
Feathers without antimicrobial treatment
Untreated feathers with Trichoderma virens fungal growth after testing using the AATCC Method 30, Part III
![Feathers treated with Ultra-Fresh]()
Feathers treated with Ultra-Fresh
Feathers treated with Ultra-Fresh antimicrobial treatment remain free of fungal growth after testing using the AATCC Method 30, Part III
![Polyurethane foam without antimicrobial treatment]()
Polyurethane foam without antimicrobial treatment
Polyurethane foam without Ultra-Fresh supports fungal growth
![Ultra-Fresh antimicrobial treated PU foam]()
Ultra-Fresh antimicrobial treated PU foam
Ultra-Fresh treated polyurethane foam prevents fungal and bacterial growth.
![Polyurethane foam without antimicrobial additive]()
Polyurethane foam without antimicrobial additive
Untreated foam used in marine seating stained pink by the pink stain organism, Streptoverticillium sp., after testing using the ASTM E1428
![Polyurethane foam with Ultra-Fresh]()
Polyurethane foam with Ultra-Fresh
Polyurethane foam, treated with Ultra-Fresh antimicrobial technology and tested using the ASTM E1428, prevents pink staining from occurring
![Vinyl roofing membrane without antimicrobial treatment]()
Vinyl roofing membrane without antimicrobial treatment
Roofing membrane without antimicrobial treatment. Tested using the ASTM G21
![Ultra-Fresh antimicrobial treated vinyl roofing membrane]()
Ultra-Fresh antimicrobial treated vinyl roofing membrane
Ultra-Fresh antimicrobial treated PVC roofing membrane protected from fungal growth after testing using the ASTM G21
![Carpet latex backing without antimicrobial additive]()
Carpet latex backing without antimicrobial additive
Latex carpet backing without antimicrobial protection supports heavy amounts of fungal growth after testing using the AATCC Method 174
![Carpet latex backing with Ultra-Fresh]()
Carpet latex backing with Ultra-Fresh
Ultra-Fresh antimicrobial treatment in the carpet latex backing prevents fungus from flourishing. Tested using the AATCC Method 174
![Polymer material without antimicrobial additive]()
Polymer material without antimicrobial additive
Clear plastic without antimicrobial treatment supports heavy amounts of fungal growth after testing using the ASTM G21 test method
![Ultra-Fresh antimicrobial treated polymer]()
Ultra-Fresh antimicrobial treated polymer
Clear plastic treated with Ultra-Fresh antimicrobial masterbatch remains free from growth after testing using the ASTM G21